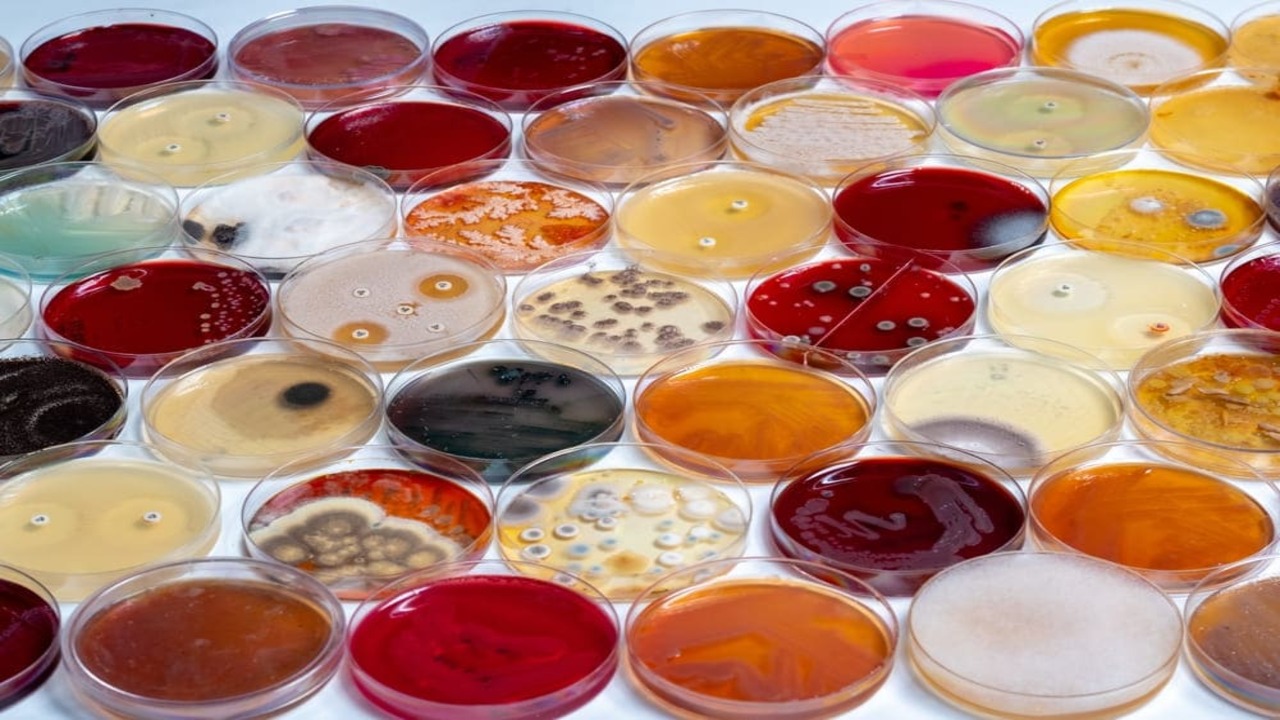
microorganismos perjudiciales

Los microrganismos perjudiciales no avisan cuando llegan. Se instalan en una junta, un tanque, una línea de producción, y de pronto lo que parecía una pequeña falla se convierte en un problema serio: lotes contaminados, equipos fuera de servicio o clientes insatisfechos.
En cualquier industria, estos visitantes invisibles pueden alterar procesos, generar pérdidas y poner en jaque la confianza que tanto cuesta construir. Por eso, entender que son, cómo actúan y qué medidas los mantienen a raya es una cuestión estratégica para la salud del negocio.
Y eso es precisamente lo que veremos en este artículo.
¿Qué son los microrganismos perjudiciales?
Los microrganismos perjudiciales son organismos microscópicos capaces de alterar la calidad, la seguridad o la estabilidad de los productos industriales. Aunque muchos microbios cumplen funciones útiles, como los empleados en fermentaciones o biotecnología, una parte de ellos genera efectos indeseados:
- deterioro de materiales,
- contaminación de lotes,
- fallas en los equipos y,
- en algunos casos, riesgos sanitarios.
Y si tenemos en cuenta los costes globales del negocio, es necesario señalar que su presencia en industrias reguladas y de alta exigencia puede implicar incumplimientos normativos, pérdidas financieras y daños a la reputación de la marca.
Tipos principales: bacterias, hongos, virus, mohos, levaduras
Entre los ejemplos de microrganismos perjudiciales más frecuentes se encuentran:
- Bacterias: como Salmonella, Listeria monocytogenes o Escherichia coli, responsables de intoxicaciones alimentarias y contaminación cruzada en líneas de producción.
- Hongos y mohos: pueden crecer en superficies húmedas o mal ventiladas, deteriorando materiales, empaques o estructuras metálicas, además de liberar esporas alergénicas.
- Levaduras: aunque muchas son útiles en procesos biotecnológicos, otras provocan fermentaciones indeseadas y alteran el pH o la viscosidad de ciertos productos cosméticos o farmacéuticos.
- Virus: su capacidad de propagación en ambientes industriales los convierte en un riesgo biológico, especialmente en espacios de manipulación de alimentos o medicamentos.
Cada grupo exige un control distinto, pero todos comparten la capacidad de adaptarse y sobrevivir en condiciones adversas si no se aplica una higiene preventiva rigurosa.
¿Cómo se multiplican y colonizan superficies, productos y ambientes?
La colonización microbiana comienza de forma imperceptible. Un residuo orgánico, una junta sin limpiar o una zona húmeda bastan para que un microorganismo encuentre alimento y empiece a reproducirse.
Las bacterias, por ejemplo, pueden duplicarse cada 30 minutos bajo condiciones favorables, formando colonias capaces de generar biofilms: capas resistentes que se adhieren a metales, plásticos o vidrios y dificultan la limpieza tradicional. Estos biofilms protegen a los microrganismos de los desinfectantes comunes, lo que explica por qué los problemas de contaminación suelen reaparecer incluso tras limpiezas frecuentes.
Factores que favorecen su crecimiento
Los factores ambientales y operativos son determinantes para el desarrollo microbiano:
- Humedad: el agua es el vehículo perfecto para su transporte y multiplicación.
- Temperatura: la mayoría de los patógenos crece entre 20°C y 45°C, aunque algunos toleran condiciones extremas.
- Residuos orgánicos: restos de materia prima o biofilm sirven como fuente de nutrientes.
- pH: los microrganismos prosperan en valores neutros o ligeramente ácidos.
- Equipos mal mantenidos: grietas, válvulas o juntas sin sanitizar son refugios habituales.
Daños causados por microrganismos perjudiciales
El impacto de los microrganismos perjudiciales trasciende el plano sanitario, especialmente en la industria. En la práctica, sus consecuencias se sienten en la salud, la calidad del producto, las finanzas y la infraestructura.
En primer lugar, están los riesgos para la salud. En la industria alimentaria o farmacéutica, una contaminación con bacterias como Listeria monocytogenes o Salmonella enterica puede causar infecciones graves y obligar a retirar lotes completos del mercado. Además de afectar al consumidor, también compromete la seguridad del personal que manipula productos biológicamente activos.
Desde el punto de vista productivo y operativo, los microorganismos generan alteraciones en la textura, el olor o la composición química de los materiales. En cosmética, por ejemplo, pueden descomponer emulsionantes o aceites esenciales; en farmacéutica, reducir la eficacia de un principio activo; y en el aluminio o la construcción, degradar pinturas, lubricantes o adhesivos.
Las consecuencias financieras tampoco son menores. Paradas de línea, pérdida de materia prima, reclamos de clientes y sanciones regulatorias representan costos directos e indirectos que afectan la rentabilidad. Tenemos el ejemplo de la marca Cadbury que, debido al retiro de chocolate contaminado por salmonela en 2006, las ventas de chocolate de la compañía cayeron aproximadamente un 14%.
Presencia de microrganismos en distintos procesos e industrias
Los microrganismos perjudiciales se comportan como oportunistas: aprovechan cualquier punto débil en los procesos industriales para proliferar. Su presencia es transversal, como hemos visto en la sección anterior, aunque las consecuencias varían según la naturaleza de la industria.
- Industria alimentaria: tanques, pasteurizadores o llenadoras pueden albergar bacterias termorresistentes o esporas fúngicas. Las limpiezas incompletas y las fluctuaciones de temperatura son terreno fértil para Salmonella, Bacillus cereus o Pseudomonas.
- Industria farmacéutica: el riesgo principal radica en la contaminación cruzada durante la formulación o envasado. Burkholderia cepacia y Staphylococcus aureus son ejemplos comunes en ambientes húmedos y poco ventilados.
- Industria cosmética: los productos con base acuosa pueden contaminarse con levaduras o mohos, provocando cambios en la viscosidad, color u olor, además de riesgos dermatológicos.
- Industria del aluminio: en los sistemas de enfriamiento o anodizado, los biofilms bacterianos pueden reducir la conductividad térmica y favorecer la corrosión microbiológica.
- Construcción: los hongos y bacterias anaerobias afectan adhesivos, pinturas o recubrimientos, generando manchas, desprendimientos o pérdida de adherencia.
- Agroindustria: las líneas de riego, tanques y equipos de almacenamiento son propensos al crecimiento microbiano que compromete la calidad del agua y la conservación de granos o cultivos.
Estos ejemplos de microrganismos perjudiciales en los distintos sectores demuestran que la prevención no es solo una cuestión de limpieza, sino de control integral del entorno.
Estrategias de control y prevención de microorganismos perjudiciales
Controlar los microrganismos perjudiciales exige un enfoque integral que combine buenas prácticas de limpieza, monitoreo constante y el uso de productos con eficacia comprobada. Además de eliminarlos, el objetivo es impedir que los patógenos encuentren las condiciones para desarrollarse.
Una estrategia efectiva comienza con un análisis microbiológico periódico de superficies, equipos y materias primas, que permita detectar focos de contaminación antes de que se conviertan en un problema. A esto se suma la implementación de planes de limpieza y desinfección (PLD) validados, donde se definan productos, concentraciones, frecuencias y modos de aplicación.
Por otro lado, el control de parámetros ambientales (como temperatura, humedad y ventilación) es fundamental para evitar la formación de biofilms. También resulta esencial la capacitación del personal, ya que un protocolo inadecuado puede anular la eficacia de un desinfectante o generar resistencias microbianas.
Por último, las empresas más avanzadas integran estas acciones en sistemas de gestión de inocuidad y calidad (como ISO 22000 o BPM), donde cada proceso se audita y optimiza continuamente. Lo que nos lleva al siguiente punto sumamente importante a tener en cuenta.
Normativas y estándares que regulan los microrganismos perjudiciales
El manejo de los microrganismos perjudiciales está regulado por un marco normativo riguroso que varía según la industria y la región, pero que comparte un objetivo común: proteger la salud pública y garantizar la calidad de los productos.
En Argentina, el SENASA establece límites microbiológicos para alimentos y bebidas, mientras que la ANMAT regula la producción farmacéutica y cosmética bajo las Buenas Prácticas de Manufactura (BPM).
En el ámbito internacional, destacan las normas ISO 22000 (gestión de inocuidad alimentaria), ISO 14644 (control microbiológico en salas limpias), y los lineamientos del Codex Alimentarius y la FDA para la gestión de riesgos biológicos.
OXIBAC® – SILVER como solución definitiva
En el control de microrganismos perjudiciales, la tecnología marca la diferencia. OXIBAC® – SILVER es un desinfectante de nueva generación que combina peróxidos estabilizados y nanopartículas de plata, logrando una acción bactericida, virucida y fungicida de amplio espectro.
Su eficacia ha sido comprobada frente a microorganismos como Staphylococcus aureus, Pseudomonas aeruginosa, Candida albicans y Aspergillus niger, entre otros. Además, es biodegradable, no corrosivo y libre de cloro, convirtiéndolo en una alternativa segura para diferentes superficies y materiales.
Gracias a su formulación avanzada, OXIBAC® – SILVER actúa incluso sobre biofilms y zonas de difícil acceso, rompiendo la estructura celular y evitando la recolonización microbiana. Puede aplicarse en
- galpones,
- laboratorios,
- líneas de producción,
- vehículos,
- sistemas de enfriamiento y
- cualquier entorno donde la higiene sea crítica.
Otro aspecto a considerar es que cuenta con aprobación de ANMAT y SENASA como desinfectante, apto para diferentes sectores industriales, incluyendo la industria alimentaria. Esto garantiza su eficacia, seguridad y trazabilidad conforme a las normas de higiene más exigentes del mercado.
Ahora bien, OXIBAC® – SILVER está destinado al tratamiento de ambientes. Se utiliza específicamente en naves, galpones, así como en la fumigación de entradas, salidas y equipos, garantizando condiciones higiénicas en espacios físicos y superficies expuestas.
En cambio, cuando se aborda el tratamiento del agua destinada a la bebida animal, se recomienda emplear AQUA NOVA – SILVER®, formulado para actuar directamente en sistemas de agua, asegurando su calidad microbiológica sin afectar la salud ni el rendimiento de los animales.
*Ambos productos están avalados por el INTA contra la gripe Aviar en un 99.99% de efectividad.
Como ves, mantener a raya los microrganismos perjudiciales no es cuestión de rutina, sino de estrategia. Apostar por soluciones certificadas y eficientes te permitirá proteger procesos, productos y reputación con resultados medibles. En PSQ te ayudamos a elegir las mejores soluciones para tu industria.


